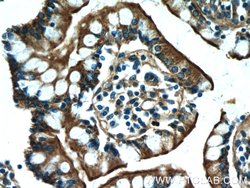
MYO1A Rabbit anti-Human, Mouse, Rat, Polyclonal, Proteintech 20 &mu;L | Buy Online | Proteintech | Fisher Scientific

missing translation for 'onlineSavingsMsg'
Learn More
Learn More
Description
The protein encoded by this gene belongs to the myosin superfamily. Myosins are molecular motors that, upon interaction with actin filaments, utilize energy from ATP hydrolysis to generate mechanical force. Each myosin has a conserved N-terminal motor domain that contains both ATP-binding and actin-binding sequences. Following the motor domain is a light-chain-binding ′neck′ region containing 1-6 copies of a repeat element, the IQ motif, that serves as a binding site for calmodulin or other members of the EF-hand superfamily of calcium-binding proteins. At the C-terminus, each myosin class has a distinct tail domain that serves in dimerization, membrane binding, protein binding, and/or enzymatic activities and targets each myosin to its particular subcellular location. The kidney epithelial cell line, LLC-PK1-CL4 (CL4), forms a well ordered brush border (BB) on its apical surface. Experiments indicate that the brush border population of the encoded protein turns over rapidly, while its head and tail domains interact transiently with the core actin and plasma membrane, respectively. A rapidly exchanging pool of the protein encoded by this gene envelops an actin core bundle that, by comparison, is static in structure.
Specifications
Specifications
| Antigen | MYO1A |
| Applications | Immunohistochemistry (Paraffin), Western Blot, Immunocytochemistry, Immunoprecipitation, Immunofluorescence |
| Classification | Polyclonal |
| Concentration | 0.2 mg/mL |
| Conjugate | Unconjugated |
| Formulation | PBS with 50% glycerol and 0.02% sodium azide; pH 7.3 |
| Gene | MYO1A |
| Gene Accession No. | O88329, Q62774, Q9UBC5 |
| Gene Alias | BBM I, BBMI, Brush border myosin I, DFNA48, MIHC, MYHL, MYO1A, Myosin I heavy chain, myosin IA |
| Gene Symbols | Myo1a |
| Show More |
Product Title
By clicking Submit, you acknowledge that you may be contacted by Fisher Scientific in regards to the feedback you have provided in this form. We will not share your information for any other purposes. All contact information provided shall also be maintained in accordance with our Privacy Policy.
Spot an opportunity for improvement?